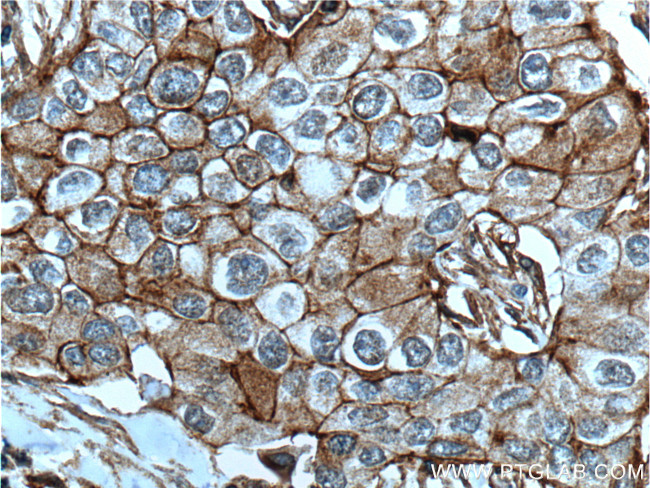
CXCR7 Antibody in Immunohistochemistry (Paraffin) (IHC (P))

Search
Proteintech
CXCR7 Monoclonal Antibody (4C3D7)
{{$productOrderCtrl.translations['antibody.pdp.commerceCard.promotion.promotions']}}
{{$productOrderCtrl.translations['antibody.pdp.commerceCard.promotion.viewpromo']}}
{{$productOrderCtrl.translations['antibody.pdp.commerceCard.promotion.promocode']}}: {{promo.promoCode}} {{promo.promoTitle}} {{promo.promoDescription}}. {{$productOrderCtrl.translations['antibody.pdp.commerceCard.promotion.learnmore']}}
产品信息
60216-1-IG
种属反应
宿主/亚型
分类
类型
克隆号
抗原
偶联物
形式
浓度
规格
纯化类型
保存液
内含物
保存条件
运输条件
产品详细信息
This antibody recognizes endogenous CXCR7, which has an experimentally determined molecular weight of 50 kDa.
Immunogen sequence: LLDIFSILH YIPFTCRLEH ALFTALHVTQ CLSLVHCCVN PVLYSFINRN YRYELMKAFI FKYSAKTGLT KLIDASRVSE TEYSALEQST K (273-362 aa encoded by BC036661)
靶标信息
This gene encodes a member of the G-protein coupled receptor family. Although this protein was earlier thought to be a receptor for vasoactive intestinal peptide (VIP), it is now considered to be an orphan receptor, in that its endogenous ligand has not been identified. The protein is also a coreceptor for human immunodeficiency viruses (HIV). Translocations involving this gene and HMGA2 on chromosome 12 have been observed in lipomas.
仅用于科研。不用于诊断过程。未经明确授权不得转售。
生物信息学
蛋白别名: Atypical chemokine receptor 3; C Cmotif chemokine; C X C motif chemokine; C-X-C chemokine receptor type 7; CC motif chemokine; CCmotif chemokine; chemokine; chemokine (C-X-C motif) receptor 7; Chemokine orphan receptor 1; CXC; CXC motif chemokine; CXC-R7; G protein-coupled receptor; G-protein coupled receptor 159; G-protein coupled receptor RDC1 homolog; RDC-1; unnamed protein product
基因别名: ACKR3; AW541270; CMKOR1; CXC-R7; CXCR-7; CXCR7; GPR159; RDC-1; RDC1
UniProt ID: (Human) P25106, (Mouse) P56485
Entrez Gene ID: (Human) 57007, (Mouse) 12778